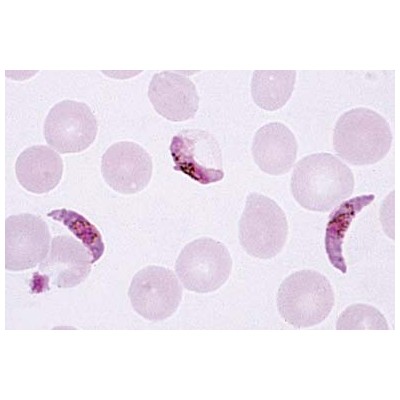
This image has an empty alt attribute; its file name is 27840_400x400.jpg

Where to begin, with this “Frankenstein of the week” story? The recluse spider, whose brew of toxins perhaps earns it an overly bad rep? True, humans occasionally pick up the Hybrid toxin, its name perhaps inspired by a Marvel superhero. Malaria is arguably the world’s most debilitating microbial disease, for human and animal death and morbidity, as well as economic impact. Every few decades another antimalarial med or insecticide is spread across the malaria belts of Africa and Asia, only to fail a decade later as resistant pathogens arise. Spread by the Anopheles mosquito, the parasite invades red blood cells, crowding the blood with Plasmodium parasites, and spreading to the bite of new mosquitoes.
Malaria is arguably the world’s most debilitating microbial disease, for human and animal death and morbidity, as well as economic impact. Every few decades another antimalarial med or insecticide is spread across the malaria belts of Africa and Asia, only to fail a decade later as resistant pathogens arise. Spread by the Anopheles mosquito, the parasite invades red blood cells, crowding the blood with Plasmodium parasites, and spreading to the bite of new mosquitoes.
The latest entrant into our malaria arms race is the fungus, Metarhizium pingshaense. This previously obscure fungus is known for attacking mosquitoes. Here we see a hapless Anopheles mosquito dying a gruesome death, thanks to fungal attack. The fungus paints the mosquito green, from a plasmid (DNA circle) that genetically engineered the fungus to express green fluorescent protein (GFP). GFP originally comes from a jellyfish, carried by a bacterial plasmid—before the GFP gene got immortalized by Roger Tsien and others, engineered into a rainbow of variously-colored fluorescent proteins.
So can we enlist Metarhizium as a weapon against the mosquito that carries killer plasmodiums? As vicious as the fungus appears, apparently it’s not strong enough to dent the vast mosquito population. But researchers don’t give up easily. Brian Lovett, entomologist at University of Maryland, teamed up with Etienne Bilgo, Sante/Centre Muraz in Burkina Faso (and a host of others) to engineer a fungus that produces the spider toxin.

Here, Etienne Bilgo is part of a team that tested the ability of a genetically engineered fungus to kill mosquitoes that can spread malaria.
How did they make the fungus-plasmid-spider-Hybrid hybrid? That feat was reported by Paula Calabria and her team at the Butantan Institute, São Paulo, Brasil. (You can see how badly people all over the world want to fight malaria.) First, they undertook some molecular sleuthing to identify the spider gene that encodes two toxins from spider venom. The genes were spliced together to encode “Hybrid” toxin. Originally their idea was to generate an anti-venom agent to treat people poisoned by a spider bite. The hybrid toxin would be used to raise antibodies that could neutralize spider toxins.
But other researchers found another use for this toxin, which effectively destroys an insect when expressed within the insect’s hemolymph (blood-like fluid). The gene encoding the Hybrid toxin was introduced into the fungal cells by use of a plasmid vector, a circle of DNA into which the Hybrid gene was spliced using restriction enzyme-cut DNA.
How to get the fungus into the mosquitoes? The recombinant fungus was suspended in sesame oil and spread onto black sheets within experimental living quarters. The mosquitoes were infected and died, or left few offspring. Moreover, the infected insects released fungal “conidia,” the spores that grow new fungi. It remains to be seen if this new virulent Franken-fungus can persist in the environment and effectively control malaria mosquitoes. And–avoid killing other insects the ecosystem needs.

2 responses to “Spider-Toxin Franken-Fungus Fights Malaria”
Can the mosquito population evolve a defense, and if so, how quickly?
My guess is that it will evolve a defense eventually. But the fungus will also evolve and might maintain the mosquitoes at a lower population. That is what happened with Btu (Bacillus thuringiensis) and inchworms. However, many crop pests did become resistant to Btu.